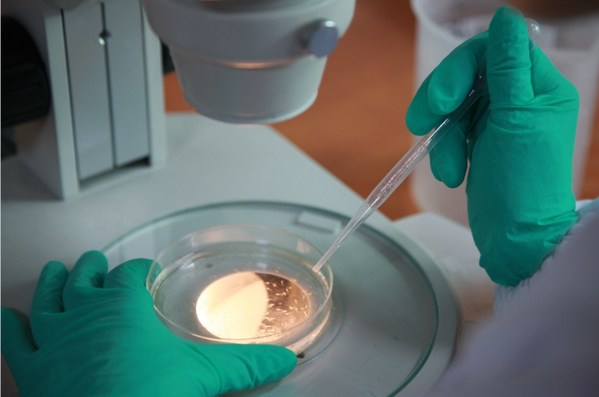
斑马鱼生物检测实验

4月15日,经中国保健协会批准,由环特生物牵头,中国标准化研究院、农业农村部食物与营养发展研究所、中国疾病预防控制中心营养与健康所及环特生物等22家企业、科研院所共同起草的团体标准 -- 《保健食品功能评价 斑马鱼试验规程》(T/CHC2003-2022)正式发布,并于2022年4月15日起正式实施。
22家团标起草单位分别为中国标准化研究院、农业农村部食物与营养发展研究所、中国疾病预防控制中心营养与健康所、中国中医科学院中药研究所、中国农业科学院农业质量标准与检测技术研究所、中国保健协会行业认证分会、中国保健协会健康服务与研究专业委员会、首都医科大学附属北京中医医院、杭州环特生物科技股份有限公司、云南贝泰妮生物科技集团股份有限公司、华熙生物科技股份有限公司、北京东方红航天生物技术股份有限公司、黑龙江飞鹤乳业有限公司、北京姿美堂生物技术有限公司、东阿阿胶保健品有限公司、漳州片仔癀药业股份有限公司、浙江养生堂天然药物研究所有限公司、健合(中国)有限公司、石家庄君乐宝乳业有限公司、碧生源控股有限公司、完美(广东)日用品有限公司、北京世标认证中心有限公司等。

团体标准信息表
该标准是环特生物携手国内22家权威科研院所、企业发布的国内首个用于食品保健功能检测的完整斑马鱼技术规程,不仅填补了我国食品保健功能检测领域斑马鱼技术规程团体标准的空白,从检测依据、斑马鱼来源和品系等信息、试验条件和方法、试验结果、数据处理与统计方法、推荐参数等关键技术内容进行了充分的实验规范规定及技术创新,其结果适用于保健食品、功能性食品及其原料和配方的功能评价,可操作性、引领性、先进性等关键指标均达到了先进水平。
而且,该标准将进一步助力我国斑马鱼技术应用标准体系的完善,全面提升我国斑马鱼技术在保健食品行业功能评价方面的标准化及应用化水平等,对行业具有重要的指导性意义与推动性作用。
斑马鱼生物检测实验
《保健食品功能评价斑马鱼试验规程》标准的发布背景及概述
近年来,社会大众的健康意识不断增强,对营养健康的需求也越来越高。《食品注册审评审批工作细则(2016年版)》要求规定,食品在注册时必须提供"配方主要原料具有功能作用的科学依据,其余原料的配伍必要性;产品配方配伍及用量具有保健食品功能的科学依据",明确了要加强食品配方的功能研究。在新的法规要求之下,如何通过技术创新来提高食品配方研发的效率和质量就显得非常迫切。

斑马鱼不同阶段图
斑马鱼作为一种小型脊椎类模式生物,其实验方法既有体外实验快速、高效的特点,又具备哺乳动物实验相关性好、预测性高的特点。在中药、营养食品的研发和评价过程中,斑马鱼实验显示出其独特优势和价值,在功效评价、安全毒理学评价及活性成分筛选等方面的应用日渐广泛,取得了显著的科研和产业化成果,目前已经可用于食品的注册申报。
在本标准的制定过程中,由环特生物牵头,中国标准化研究院及环特生物等22家企业、科研院所共同组建的标准制定团队,既结合国际标准OECD236、GB/T 39649的规定执行斑马鱼质量控制等标准体系,又结合了斑马鱼生物检测技术在国内10余年成熟的技术应用实践和经验,形成了具有中国特色的《保健食品功能评价斑马鱼试验规程》团体标准。
该标准规定了斑马鱼用于评价保健食品功能的技术要求,术语和定义、试验流程、受试样品信息确认、斑马鱼准备、试验操作、结果评价及试验报告撰写等内容,适用于保健食品、功能性食品及其原料和配方的功能评价。
以结果有效性分析为例,该标准指出,正常对照组(当使用了助溶剂,也包括溶剂对照组)斑马鱼的死亡率或异常率不得超过10%,超过10%则该次试验结果视为无效;模型对照组与正常对照组之间的原始数据存在统计学上的显著性差异,阳性对照组与模型对照组之间的原始数据存在统计学上的显著性差异,否则该次试验结果视为无效。当使用了助溶剂,溶剂对照组与正常对照组之间的原始数据不能存在统计学上的显著性差异,否则该次试验结果视为无效。
形成标准只是第一步,斑马鱼生物检测技术的发展与应用仍需要更多人的关注与参与。未来,环特生物等各起草单位将携手更多的协会、科研院所及保健食品、食品企业,进一步深化标准引领,完善标准规范的实施与应用,引领制定更高的斑马鱼检测标准,推进斑马鱼技术应用标准体系建设,助力美丽健康产业高质量发展!
(来源:温州视线)


